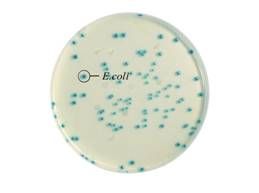
中國檢驗檢疫科學研究院
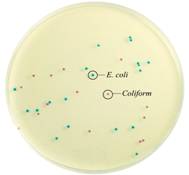
中國檢驗檢疫科學研究院
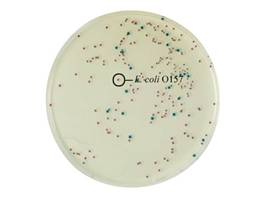
中國檢驗檢疫科學研究院

基本資料
規範性簡稱:中國檢科院
英文全稱:Chinese Academy of Inspection and Quarantine
英文縮寫:CAIQ
主要任務
中國檢驗檢疫科學研究院的主要任務是以檢驗檢疫套用研究為主,同時開展相關基礎、高新技術和軟科學研究,著重解決檢驗檢疫工作中帶有全局性、綜合性、關鍵性、突發性和基礎性的科學技術問題,並為國家檢驗檢疫決策提供技術支持。
另外,中國檢科院還承擔著國家質檢總局的部分技術執法輔助工作,承擔了國家質檢總局食品安全研究室、國家質檢總局進出口化妝品標籤審核辦公室、中國動植物檢疫風險分析委員會秘書處和全國植物檢疫標準化委員會秘書處的工作。
下設機構
中國檢科院下設食品安全研究所(國家食品安全信息中心)、動植物檢疫研究所、衛生檢疫研究所、工業品檢驗研究所、檢測技術與裝備研究所、檢驗檢疫技術情報研究所(檢驗檢疫標本館)等6個院直屬研究所,另有北京中德聯合化妝品研究所、中美檢科微技術研究所、綜合檢測中心、北京陸橋質檢認證中心(BQC),院部由辦公室、科技管理部、人力資源部、財務管理部、黨委辦公室5個職能部門組成。
硬體設施
中國檢驗檢疫科學研究院現有建築面積2萬餘平方米,各類檢測儀器設備600餘台/套,總價值約11800萬元人民幣。
人力資源
現有各類人員500餘人,有一批高級專業技術人才和國內權威技術專家,其中研究員24名,高級工程師(副研究員)41名,博士35名。建有人事部博士後科研工作站。
專業領域
專業領域涵蓋食品化學、分子生物學、動物檢疫、植物檢疫、流行病學、微生物、轉基因、紡織、輕工業品安全項目檢測技術、危險品及原材料安全評估與檢測技術等多個層面,在食品、農畜產品、植物檢疫、化工礦產品、轉基因食品和衛生檢疫檢測技術的研究及檢驗方面具有很強的技術實力。
下轄公司
中國檢科院下轄陸橋集團公司,該集團是專門從事科研成果轉換、開發、經營的高新技術企業集團。該集團包括北京陸橋技術有限責任公司、北京陸橋商檢新技術公司、三河質檢印刷有限責任公司、陸橋印刷包裝有限責任公司、北京陸橋動植物檢疫技術開發公司、北京陸橋綜合服務公司等。
學術動態
1、《微流體晶片技術及食品安全檢驗檢疫套用研究》通過專家鑑定
中國檢驗檢疫科學研究院承擔的科研院所社會公益研究專項“微流體晶片技術及食品安全檢驗檢疫套用研究”(課題編號:2005DIA2J128)於2008年4月29日在京通過了國家質檢總局科技司組織的專家鑑定。該課題並於當日通過了科技部發展計畫司委託國家質檢總局科技司組織的課題驗收。
2、《香港特區有害生物風險分析工作及修訂植物檢疫性有害生物名錄》通過專家鑑定
2007年6月,由施宗偉主持的《香港特區有害生物風險分析工作及修訂植物檢疫性有害生物名錄》(編號檢科2005-008)通過專家鑑定。
科研成果
固相萃取(SolidPhaseExtraction,簡稱:SPE))是一種用途廣泛而且越來越受歡迎的贗品前處理技術。由陸橋技術有限公司開發研製的固相萃取產品,其填料採用高純、優質的材料,經過獨特的表面改性工藝製備而得。具有國際一流的品質,經濟型和價格和齊全的品種系列。產品包括反相SPE(C18、C4等)、正相SPE(NH2、CN等)、離子交換SPE(SAX、SCX等)吸附SPE(Carb、Florisil等)。
陸橋技術有限公司以強大的技術力量為後盾,可根據用戶的特殊套用需求,量體裁衣,提供特定產品。我們不僅可根據用戶要求提供特殊產品規格(填料力度、填料質量和柱管容積),而且可根據特殊套用進行特定的表面改性,提供具有特定的吸附選擇性的產品。
顯色培養基(Chromogenic/FluorogenicCultureMedia)是一類利用微生物自身代謝產生的酶與相應顯色底物反應顯色的原理來檢測微生物的新型培養基。利用顯色培養基進行微生物的篩選分離,其反應的靈敏度和特異性大大優於傳統培養基。
目前,北京陸橋技術有限責任所開發的系列顯色培養基有:大腸桿菌與大腸菌群顯色培養基、沙門氏菌顯色培養基、金黃色葡萄球菌顯色培養基、李斯特氏菌顯色培養基、大腸桿菌O157顯色培養基以及副溶血性弧菌顯色培養基。可以廣泛套用於食品微生物檢測、衛生檢驗檢疫等方面。
中國檢驗檢疫科學研究院
中國檢驗檢疫科學研究院E.coliChromagenicAgar
用於大腸桿菌的快速鑑別和計數,18-24h可初步判定結果
微生物菌落顏色
大腸桿菌藍綠色
其他無色或被抑制
大腸桿菌和大腸菌群液體顯色培養基(LECC)
LiquidE.coli&ColiformChromagenicmedium
 中國檢驗檢疫科學研究院
中國檢驗檢疫科學研究院可同時進行大腸桿菌和大腸菌群MPN法計數,
24h可判定結果
微生物菌落顏色
大腸桿菌藍綠色、有螢光
大腸菌群藍綠色、無螢光
大腸桿菌和大腸菌群顯色培養基(ECC)
E.coli&ColiformChromagenicmedium
中國檢驗檢疫科學研究院
中國檢驗檢疫科學研究院用於大腸桿菌和大腸菌群的同時快速鑑別和計數,
18-24h可初步判定結果
微生物菌落顏色
大腸桿菌藍綠色
大腸菌群紫紅色
大腸菌群顯色培養基(CA)
ColiformChromagenicAgar
用於大腸菌群的快速鑑別和計數,18-24h可初步判定結果
微生物菌落顏色
大腸菌群藍綠色
其他無色或被抑制
沙門氏菌顯色培養基
SalmonellaeChromagenicmedium
 中國檢驗檢疫科學研究院
中國檢驗檢疫科學研究院用於沙門氏菌的選擇性分離鑑別,18-24h可初步判定結果
微生物菌落顏色
沙門氏菌(淺)紫紅色
其他藍綠色、無色,或不生長
李斯特氏菌顯色培養基
ListeriaChromagenicmedium
用於李斯特氏菌的選擇性分離鑑別,24h可初步判定結果
 中國檢驗檢疫科學研究院
中國檢驗檢疫科學研究院微生物菌落顏色
單增李斯特氏菌綠色菌落,周圍有暈圈
綿陽李斯特氏菌綠色菌落,周圍有暈圈
英諾克李特氏菌綠色菌落
大腸桿菌O157:H7顯色培養基
E.coliO157:H7Chromagenicmedium
用於大腸桿菌O157:H7的選擇性分離鑑別,
中國檢驗檢疫科學研究院
中國檢驗檢疫科學研究院24h可初步判定結果
微生物菌落顏色
大腸桿菌O157:H7紫紅色
其他大腸桿菌藍色
其他無色或被抑制
坂崎腸桿菌顯色培養基
E.SakazakiiChromagenicmedium
用於坂崎腸桿菌的選擇性分離鑑別,
 中國檢驗檢疫科學研究院
中國檢驗檢疫科學研究院24h可初步判定結果
微生物菌落顏色
坂崎腸桿菌藍綠色
大腸菌群無色菌落
金黃色葡萄球菌被抑制
弧菌顯色培養基
VibrioChromagenicmedium
 中國檢驗檢疫科學研究院
中國檢驗檢疫科學研究院微生物菌落顏色
副溶血性弧菌紫紅色
霍亂弧菌藍綠色
擬態弧菌藍綠色
用於副溶血性弧菌的分離鑑別,24h可
初步判定結果
專家介紹
龐國芳
 龐國芳
龐國芳龐國芳,中國工程院院士,國家質檢總局首席研究員,
中國檢科院首席科學家,中國食品安全國家標準審評審員會副主任,中國國家食品安全風險評估專家委員會副主任,國家級有突出貢獻中青年專家,享受國務院特殊津貼專家,國際公職化學家聯合會(AOAC)資深專家。
30餘年始終工作在檢驗檢疫第一線,致力於食品科學檢測技術理論與實踐的研究,在農藥等化學污染物殘留微量分析技術領域進行了開拓性的研究工作,在研究高靈敏度、高選擇性、高解析度的多殘留快速檢測新技術、新方法方面;在研究新型萃取、分離、富集等樣品製備新技術、新方法方面多有創新。在檢測技術標準化工程化方面頗有建樹,研究建立了139項國家技術標準和3項國際AOAC標準(其中一項正在組織AOAC協同研究),提升了相關產品的質量,促進了相關行業發展和科學技術的進步。3次榮獲國家科學技術進步二等獎,5次榮獲國際AOAC科學技術獎。論著8部(1300多萬字),論文80多篇(其中30篇SCI論文)。培養帶出了一支包括2名“新世紀百千萬人才工程”國家級專家,5名教授級研究員和6名享受政府特殊津貼專家的高水平科研團隊。
儲曉剛
 儲曉剛
儲曉剛有害物質分析與代謝機理研究首席專家,博士,研究員,食品安全研究所所長。
榮譽稱號:享受政府特殊津專家,總局優秀中青年科技工作者,國家中長期發展規劃專家,科技部863專家, 科技部公共安全發展規劃、衛生部食品安全專項、亞太地區公共安全特聘專家。
社會兼職:中國儀器儀表學會、中國分析測試協會、中國質譜學會有機分會、中國色譜學會和中國分析毒理學會會員,衛生部食品衛生標準專業委員會委員,國家標準委5個標準化專業委員會委員。任中國農業大學、江南大學、四川大學、瀋陽農大客座教授和研究生導師。
科研業績:自2004年以來,獲得國家質檢總局“科技興檢獎”一等獎4項、二等獎1項,省部級“科學技術進步獎”二等獎2項;以第一作者或通訊作者發表SCI文章17篇;獲得發明專利2項,實用新型專利5項。
研究方向:食品中未知有害物質篩查技術,複雜基質食品中有害物質分離技術,實驗材料套用研究,實驗室樣品處理設備研發,食品安全檢測技術方向戰略研究、進出口食品安全突發事件處置技術。
陳穎
 陳穎
陳穎物
種鑑定和轉基因安全研究首席專家,博士,研究員,食品安全研究所副所長。
榮譽稱號:享受政府特殊津專家,國家百千萬人才,中央國家機關優秀青年,國家質檢總局優秀女科技工作者。
社會兼職:山東農業大學客座教授,中國食品科學技術學會果蔬加工分會理事,中國食品科學技術學會青年工作委員會理事,全國生化檢測標準化委員會委員,全國生物晶片標準化技術委員會委員。
科研業績:自2004年以來,獲得國家科技進步獎二等獎1項,國家質檢總局“科技興檢獎”一等獎2項、二等獎2項;以第一作者或通訊作者發表SCI文章12篇;獲得發明專利3項。
研究方向:食品生物安全(包括:轉基因檢測、生物物種鑑別、食品真偽鑑別,微生物分子生物快速檢測等)。
范春林
 范春林
范春林,農產品質量安全化學污
染物檢測、監測與溯源技術研究首席專家學士研究員,享受國務院政府特殊津貼專家,新世紀百千萬人才,國家質檢總局優秀中青年專家。
研究方向:農產品中化學污染物檢測、監測技術研究,農產品及農產品中化學污染物溯源技術研究。
獲國家科技進步獎二等獎3項,國家質檢總局“科技興檢獎”一等獎1項、二等獎1項,省部級科學技術獎一等獎1項,發表SCI文章27篇,制定國際AOAC標準2項,出版專著8部(1700萬字)。
朱水芳
 朱水芳
朱水芳植
物病害檢疫與預警研究首席專家,博士,研究員,動植物檢疫研究所所長。
榮譽稱號:享受政府特殊津專家,中央直控專家,國家百千萬人才,質檢總局先進個人,先進科技工作者,國家中長期科技規劃專家,科技部863專家,ISO轉基因技術委員會專家,,國家發改委生物產業諮詢專家。
社會兼職:國家農業轉基因生物安委會委員,第九屆國際植保大會分會主席,第十屆國際植病大會分會主席。
科研業績:自2004年以來,獲國家科技進步獎二等獎1項,國家質檢總局“科技興檢獎”一等獎2項、二等獎1項,中國“標準創新貢獻獎”二等獎1項;以通訊作者發表SCI文章3篇;獲得發明專利5項。
研究方向:生物安全及檢驗檢疫安全國家戰略規劃,轉基因生物安全評價與檢驗,外來有害生物入侵規律、成災機理、偵檢與防控技術研究等。
林祥梅
 林祥梅
林祥梅動物檢疫與人畜共患病研究首席專家,博士,研究員,動植物檢疫研究所副所長。
榮譽稱號:國家質檢系統抗擊“非典”先進個人榮譽稱號,中國檢科院“先進個人”、中國檢科院“先進中層幹部”、中國檢科院“優秀共產黨員”稱號。
社會兼職:中國畜牧獸醫學會動物檢疫學分會副秘書長。
科研業績:自2004年以來,獲國家質檢總局“科技興檢獎”二等獎3項;以第一作者發表SCI文章1篇;獲得發明專利2項,實用新型專利1項。
王超
工業(消費)產品安全研究首席專家,碩士,研究員,工業品檢驗研究所所長。
 王超
王超社會兼職:中國國家實驗室認可技術委員會委員,中華
中醫藥學會中藥分析分會副主任委員,國家化學危險品標準化技術委員會委員。
科研業績:自2004年以來,獲國家質檢總局“科技興檢獎”三等獎2項;以第一作者或通訊作者發表SCI文章3篇。
研究方向:工業消費品有害因子檢測關鍵技術及風險評估研究;工業消費產品的安全法規、技術標準和規範的比較研究;工業消費品中新材料檢測關鍵技術及其套用技術的研究。
王靜
外來傳染病研究首席專家,博士,研究員。
 王靜
王靜榮譽稱號:中央國家機關十佳傑出青年,中央國家機關
優秀青年,質檢系統先進個人(記一等功),質檢總局優秀青年,質檢總局優秀共產黨員。
社會兼職:中國微生物學會微生物毒素專業委員會委員,中華預防醫學會衛生檢驗專業委員會委員,國家病原微生物衛生應急實驗室網路專家委員會委員
科研業績:自2004年以來,獲國家質檢總局“科技興檢獎”一等獎2項,二等獎2項;獲得發明專利4項,實用新型專利2項。
研究方向:外來傳染病及其媒介生物監測、檢測、溯源及預警研究。
王躍進
 王躍進
王躍進檢
疫處理研究首席專家,學士,研究員,檢測技術與裝備研究所 常務副所長。
榮譽稱號:享受政府特殊津專家,國家質檢總局優秀中青年專家,國家質量監督檢驗檢疫先進個人。
社會兼職:中國植物保護學會理事,中國糧油學會理事,中國糧油學會儲藏專業分會常務理事,IPPC植物檢疫處理技術專家組成員,國際森林檢疫專家組成員,國際儲藏物氣調與熏蒸大會常設委員會委員。
科研業績:自2004年以來,獲國家質檢總局“科技興檢獎”一等獎1項;以第一作者發表SCI文章1篇;獲得實用新型專利5項。
鄒明強
 鄒明強
鄒明強現場
快速檢驗檢疫研究首席專家,博士,研究員,檢測技術與裝備研究所副所長。
榮譽稱號:享受政府特殊津專家,總局首屆中青年專家。
社會兼職:全國納米標準化技術委員會委員,中國儀器儀表學會科學儀器學術委員會委員,中國儀器儀表學會檢驗檢疫儀器套用分會常務副秘書長,中國譜學學會理事,《現代科學儀器》期刊編委。
科研業績:自2004年以來,獲省部級科技成果一等獎1項、二等獎5項;以第一作者或通訊作者發表SCI文章12篇;獲得實用新型專利1項。
研究方向:納米生物、小型拉曼、微流控晶片、流式微球免疫篩查等前沿分析科學及裝備的研究與開發。
陳會明
 陳會明
陳會明化
學品安全研究首席專家,博士,研究員進出口化學品安全研究中心主任。
榮譽稱號:中國檢科院先進工作者,優秀中層幹部,國家質檢總局應對REACH專家工作組首席專家。
社會兼職:國家認監委檢驗檢疫標準化政策研究工作組組長,全國危標委化學品毒性檢測分技術委員會秘書長,中國毒理學會環境與生態毒理學專業委員會副主任委員,,中華預防醫學會衛生毒理分會委員,全國化學標準化技術委員會委員。
科研業績:自2004年以來,獲國家質檢總局“科技興檢獎”二等獎2項;以第一作者發表SCI文章6篇。
研究方向:化學品戰略與政策;化學品風險分析;化學品信息平台;化學品安全、衛生和環保(EHS)評價新檢測技術。
相關詞條
| 中國科學院植物研究所 | 中國科學院聲學研究所 | 中國科學院金屬研究所 |
| 中國科學院數學研究所 | 中國科學院上海微系統與信息技術研究所 | 中國科學院微電子研究所 |
| 中國科學院生物物理研究所 | 中國科學院山西煤炭化學研究所 | 中國科學院高能物理研究所 |
| 中國科學院上海矽酸鹽研究所 | 中國農業科學院北京畜牧獸醫研究所 | 七二五所 |
| 北京生命科學研究所 | 中國科學院南京地質古生物研究所 | 中國科學院瀋陽自動化研究所 |
| 北京機械工業自動化研究所 | 中國科學院微生物研究所 | 上海社會科學院歷史研究所 |
| 中國科學院有機化學研究所 | 中國科學院合肥智慧型機械研究所 | 中國科學院自然科學史研究所 |
| 上海電器科學研究所 | 中國科學院成都生物研究所 | 中國科學院固體物理研究所 |
| 中國科學院武漢岩土力學研究所 | 天津市醫學科學技術信息研究所 | 環境保護部南京環境科學研究所 |
| 中國科學院上海細胞生物學研究所 | 中國科學院武漢病毒研究所 | 中國科學院南京地理與湖泊研究所 |

